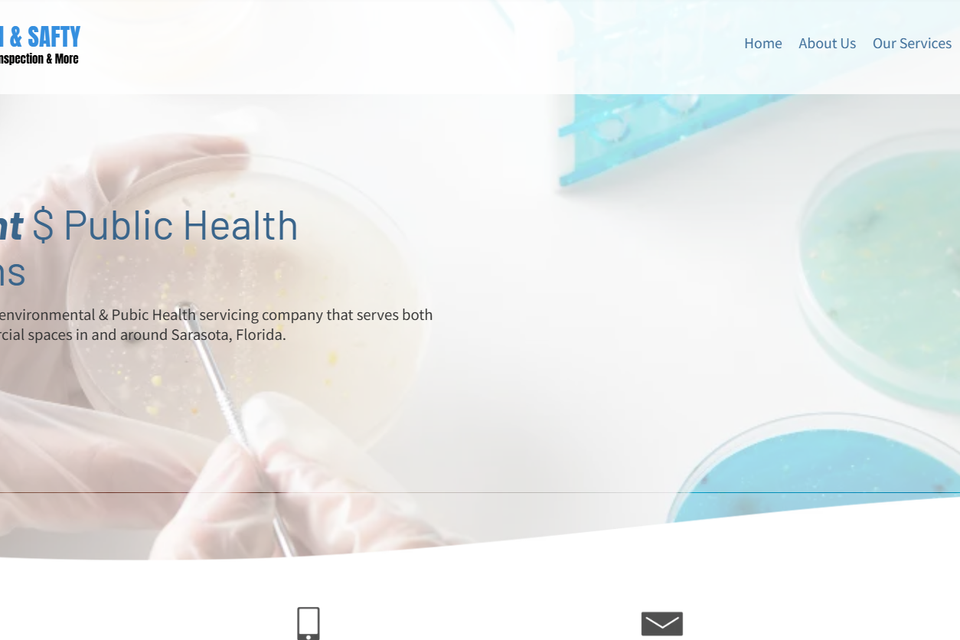
Screenshot (921)

Your friendly Agency in Texas & Florida
Website Design & Digital Agency
At SWS, we offer high-quality, affordable websites for small businesses.
From website design and SEO, to social media and beyond, we'll help you grow your business online.
From website design and SEO, to social media and beyond, we'll help you grow your business online.